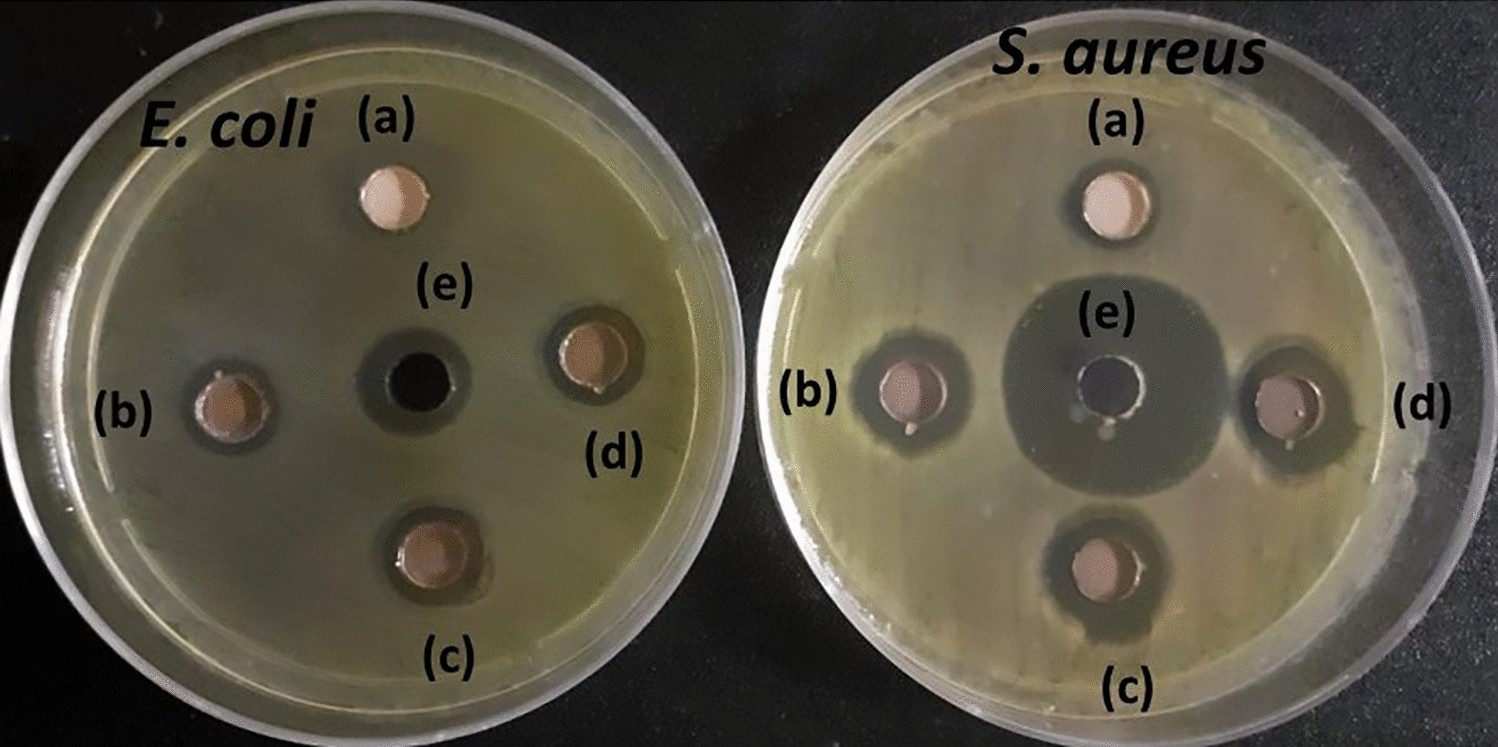
Figure 12

Figure 12

Antibacterial activity showing ZOIs for (a) ZnO, (b) Ag0.2@ZnO, (c) Ag0.4@ZnO, (d) Ag0.8@ZnO NCs (2 mg; 40 mg/mL), and (e) ampicillin (positive control) against E. coli and S. aureus.
Antibacterial activity showing ZOIs for (a) ZnO, (b) Ag0.2@ZnO, (c) Ag0.4@ZnO, (d) Ag0.8@ZnO NCs (2 mg; 40 mg/mL), and (e) ampicillin (positive control) against E. coli and S. aureus.